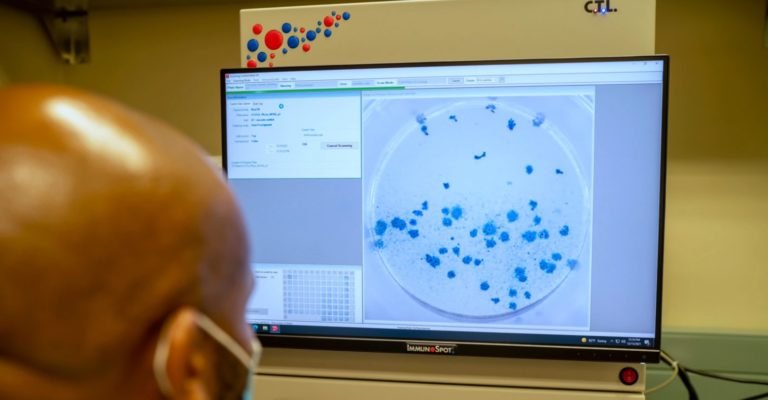
Nuevo estudio sugiere que la infección por ómicron refuerza la inmunidad frente a delta

Últimas
- Secretario PLN le exige al Gobierno “no más impuestos”
- La “escalada” de la mezquindad y la “mala hierba”
- Sala IV ordena al Minae y Setena incluir el cambio climático en evaluaciones de impacto ambiental
- La próxima elección de dos jueces en la Corte Internacional de Justicia (CIJ): algunas reflexiones
- Diputado del PLN exige renuncia del ministro de Seguridad tras incidente en Crucitas